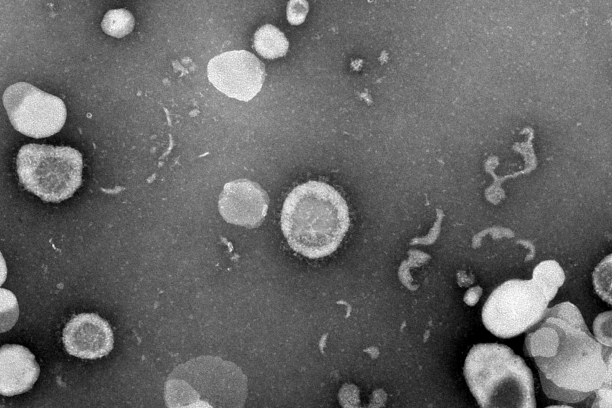

Pathologic tissue inflammation drives chronic inflammatory diseases, including allergy and autoimmune disease. In the Pua lab, we study how small non-coding RNAs (especially miRNAs) regulate tissue inflammation through their ability to control gene expression programs in T cells and macrophages. We are interested in both the cell-intrinsic functions of these RNAs as well as their ability to communicate signals between cells in vivo during inflammation. We use RNA biology’s molecular toolkit in combination with classic cellular immunology to address these fundamental questions of molecular pathogenesis.